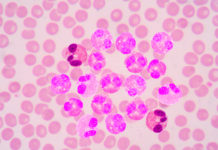

Архив
Злокачественная глиома
Заболеваемость Заболеваемость злокачественной глиомой достигает 5 случаев на 100 тыс. Злокачественная глиома может развиваться в любом возрасте, пик заболеваемости приходится на 5-6 декады жизни. Диагноз Злокачественная глиома...
Меланома кожи
Заболеваемость Средний показатель заболеваемости меланомой кожи варьирует от 3-5 случаев на 100 тыс. чел. в год в странах Средиземноморья до 12-20 случаев на 100 тыс....
Саркома мягких тканей
Заболеваемость Саркомы мягких тканей являются редкими опухолями, заболеваемость в Европе составляет 5,0 случая на 100 тыс. чел. в год. Диагноз Саркомы мягких тканей могут иметь любую локализацию,...
Смешанные и несеминомные герминогенные опухоли
Заболеваемость Заболеваемость опухолями яичка в Европе удваивается каждые 20 лет. В среднем заболеваемость раком яичка в Европе составляет 6,3 на 100 тыс. чел. мужского населения,...
Семинома яичка
Заболеваемость Заболеваемость опухолями яичка в Европе удваивается каждые 20 лет. В среднем заболеваемость раком яичка в Европе составляет 6,3 на 100 тыс. чел мужского населения,...
Хронический миелоидный лейкоз (ХМЛ)
Заболеваемость Заболеваемость в Соединенных Штатах Америки составляет 1-2 случая на 100 тыс. человек в год при отсутствии существенных географических различий. Возрастная медиана на момент диагноза составляет...
Лимфома Ходжкина
Заболеваемость Заболеваемость лимфомой Ходжкина (ЛХ) в странах Европейского союза составляет 2,2 случаев на 100 тыс. человек в год, а смертность ― 0,7 случаев на 100...
Вновь диагностированные и рецидивные фолликулярные лимфомы
Заболеваемость Фолликулярные лимфомы представляют второй по частоте встречаемости подтип нодальных злокачественных лимфом. Заболеваемость быстро повышается на протяжении последних десятилетий и с 1950 года увеличилась с...
Первично диагностированные и рецидивные диффузные В-крупноклеточные лимфомы
Заболеваемость Крупноклеточные лимфомы составляют 30%-58% всех неходжкинских лимфом. Заболеваемость в Европейском Союзе составляет 5-6 случаев на 100 тыс. чел. в год. Частота заболеваемости увеличивается с...
Хронический лимфоцитарный лейкоз (ХЛЛ)
Заболеваемость Хронический B-клеточный лимфоцитарный лейкоз (В-ХЛЛ) наиболее частый вид лейкоза среди населения западного полушария, показатель заболеваемости составляет 4 случая на 100 тыс. чел. в год....